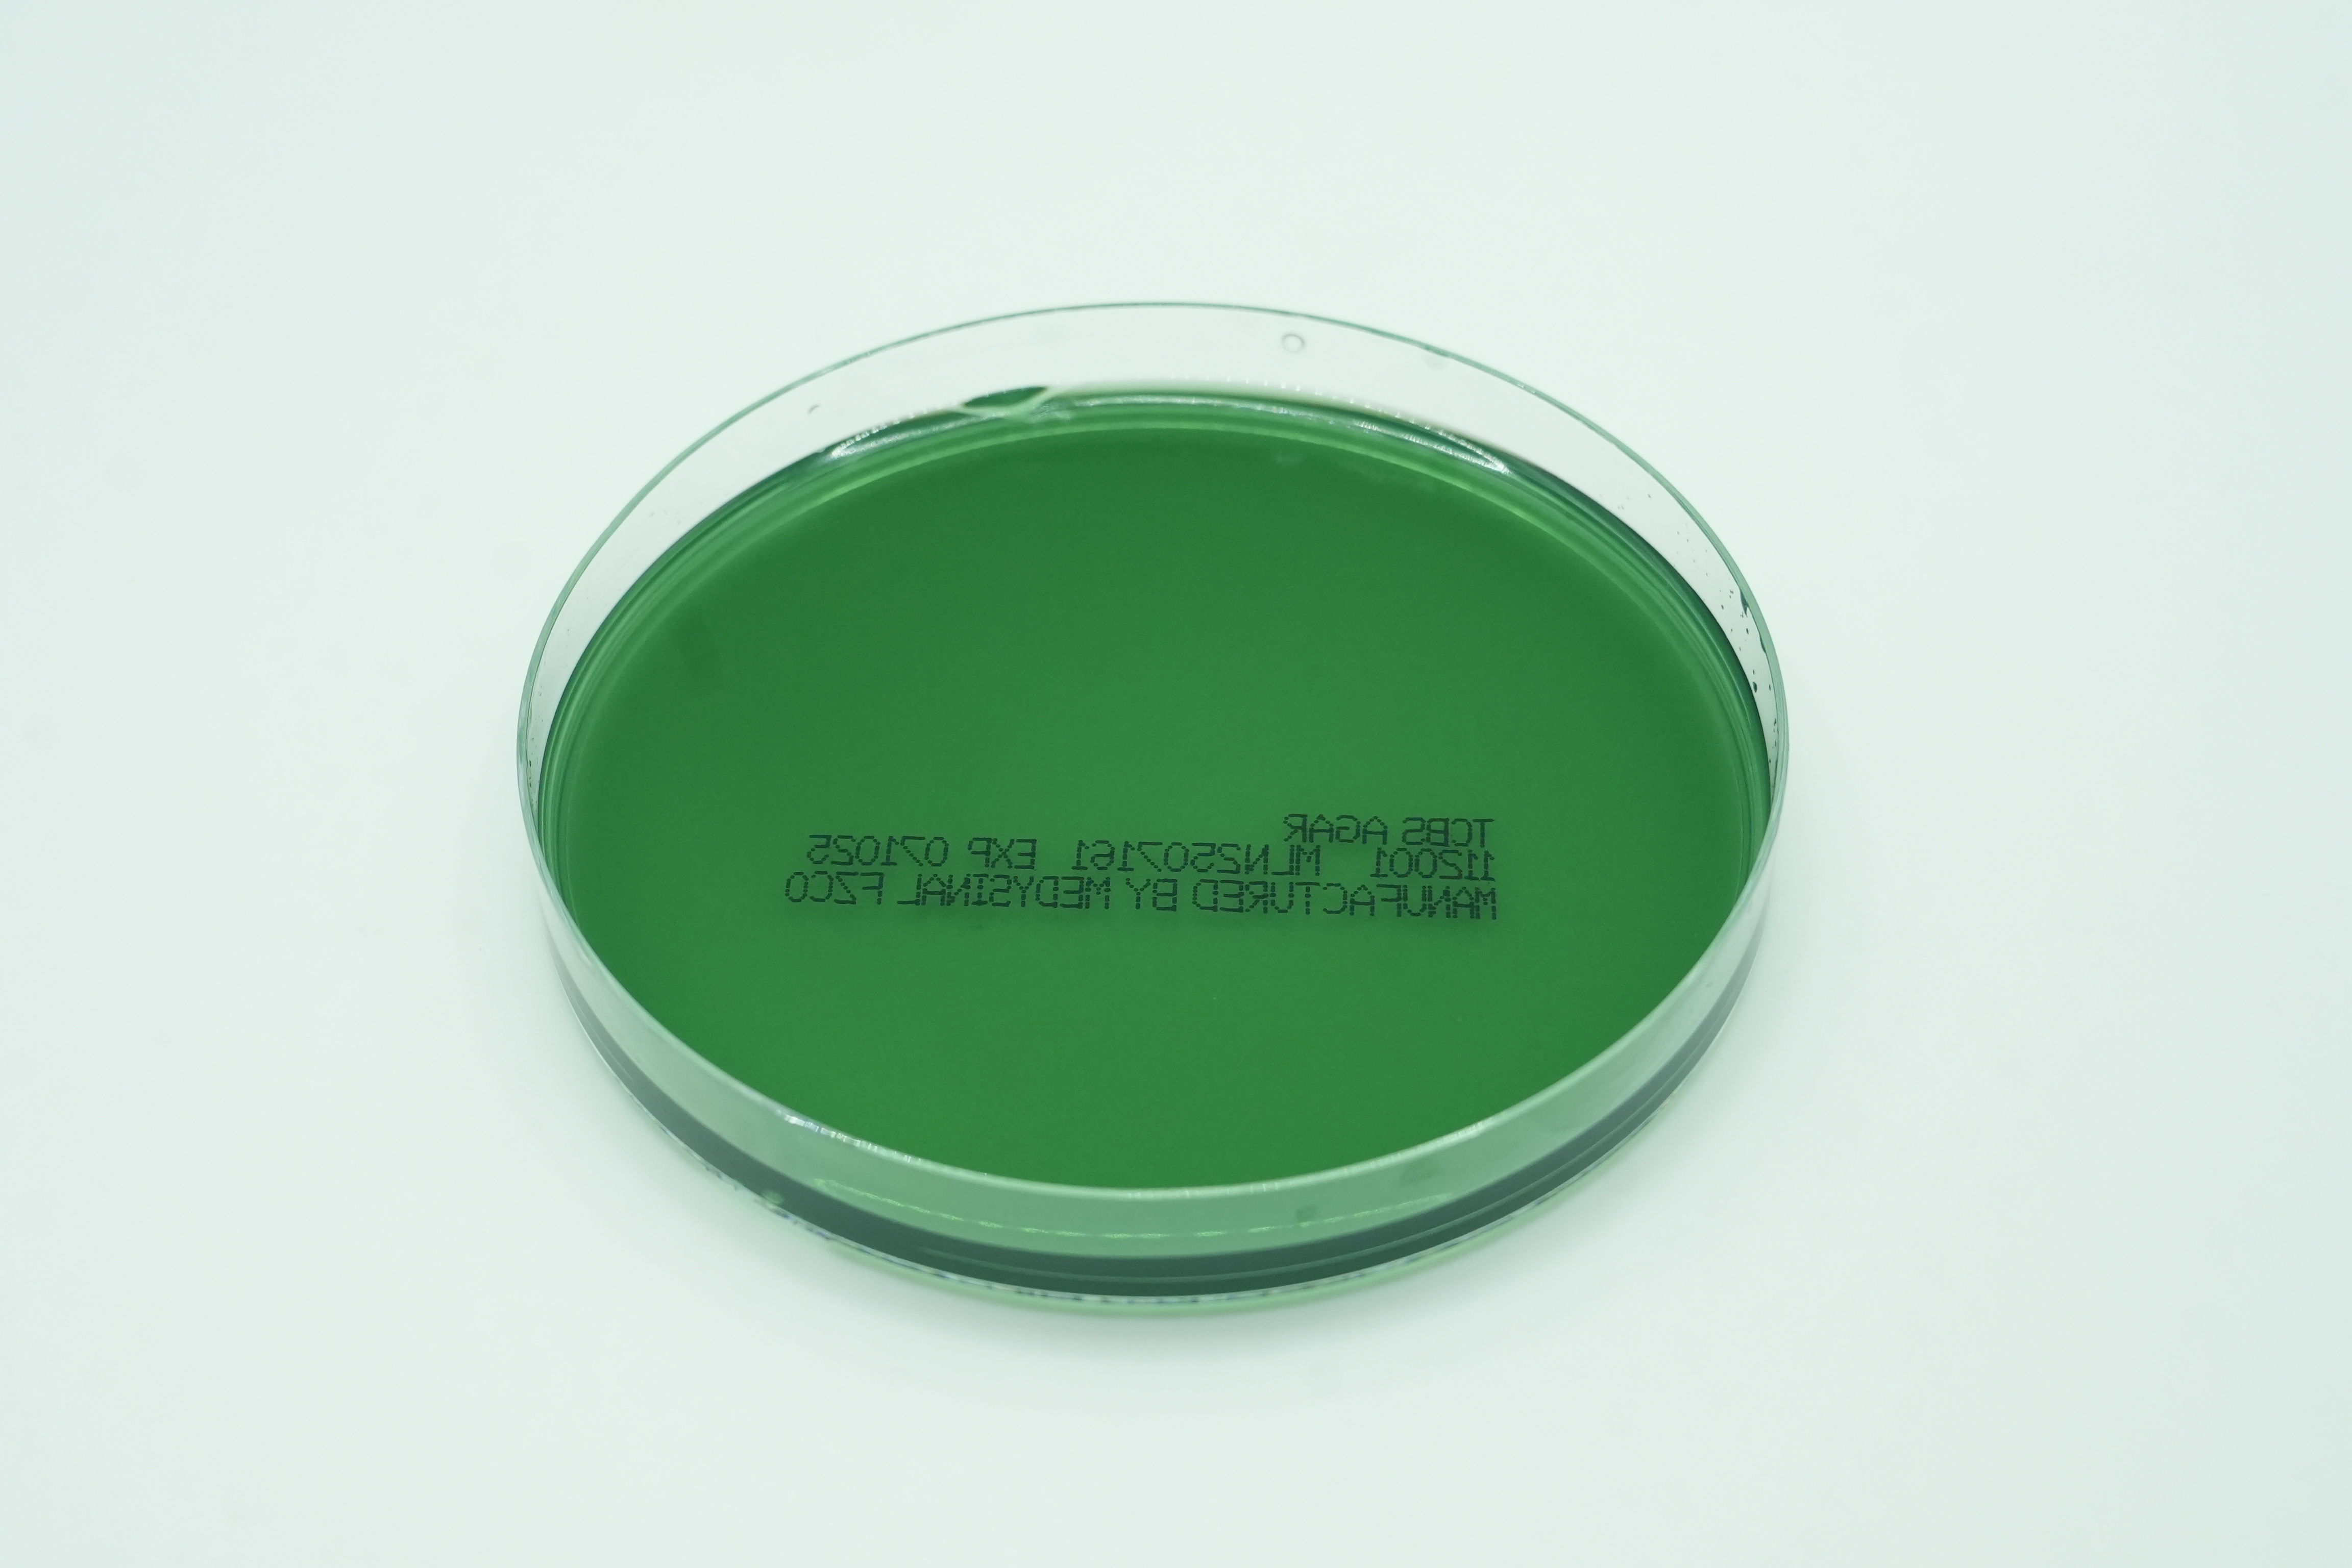

Thank you for your interest We will reach out to you

Oops! Something went wrong while submitting the form.
.svg)
Find a Product
Thank you! Your submission has been received!
Oops! Something went wrong while submitting the form.

Orange Serum Agar
321501

Schaedler Agar
111903

Selectrol® Escherichia coli O157 non-toxigenic NCTC® 12900 / ATCC® 700728

Trypticase Soy Agar W Beta-Lactamase, Rodac Plates
112011

Eosin Methylene Blue (EMB) Agar
110501

Pseudosel Agar(Cetrimide)
111603

Blood/MacConkey Agar Biplate
120401

Yeast Extract Agar 90MM
110238

Selectrol® Lactobacillus brevis NCTC® 13386 / ATCC® 8287

G.C. Agar
110313

Chrom Candida PLUS
110340

Bordetella Gengou Agar
110206

Columbia CNA Blood Agar/MacConkey Agar Biplate
120413

Pseudomonas Cepacia Medium
111611

Selectrol® Streptococcus pyogenes NCTC® 12696 /ATCC® 19615

SABHI Agar
111913

Selectrol® Enterococcus hirae NCTC® 13383 /ATCC® 10541

CHROMagar Y.enterocolitica
110332

Violet Red Bile Glucose (VRBG) Agar
112201

Trypticase Soy Agar Slants
4321086

Cled Agar
110305

Bismuth Sulphite Agar (BSI) 90MM
110218

Motility Test Medium
4321509

Selectrol® Candida albicans NCPF® 3179 / ATCC® 10231

BCYE Selective Agar
110217

TSB w/ 15% Glycerol
4397809

MEndo LES Agar 60MM
113005

Selectrol® Raoultella planticola NCTC® 9528 formerly Klebsiella aerogenes
Thiosul. Citrate Bile Salts Sucr. (TCBS) Agar
112001

Novuhair
110107

Selectrol® Staphylococcus aureus NCTC® 10788 / ATCC® 6538

Selectrol® Escherichia coli NCTC® 12923 / ATCC® 8739

Selectrol® Pseudomonas paraeruginosa NCTC® 12924 / ATCC® 9027
%201.png)
Mueller Hinton Broth (5 ml)
4397220

MR-VP Test Medium
4321667

Mannitol Selenite F-Broth
4321022

Campylobactor BLD-Free Sel. Medium
110316

Violet Red Bile Glucose Agar 90MM
112201

Sab Dex w Chlormphenicol & Cycloheximide
419002

Mueller Hinton Agar
111305

Chocolate/Martin Lewis Agar Biplate
120304

Selectrol® Streptococcus agalactiae NCTC® 8181 / ATCC® 13813

Selectrol® Pseudomonas aeruginosa NCTC® 13359 / ATCC® 15442

Trypticase Soy Agar w 2% NaCl
112005

Chrom Strep B/Columbia CNA Biplate
120410
%20Slants%201.png)
Loweinstein-Jensen (LJ) Slants
4321387

Chromogenic MRSA Agar
110315

Selectrol® Staphylococcus aureus NCTC® 13373 / ATCC® 43300

CHROMagar Staph aureus
110331

Blood/MacConkey without CV Agar Biplate
120402

MILK AGAR
111316

Selectrol® Proteus mirabilis NCTC® 10975

Selectrol® Proteus mirabilis NCTC® 13376 / ATCC® 14153

Lim Broth
412001

Sab. Dex Agar with Chloremphenicol
111909

Selectrol® Saccharomyces cerevisiae NCTC® 10716 / ATCC® 9763

CHROM Campylobacter Agar
110338

Endo Agar
110502

Gram's Decolorizer
1003

Selectrol® Staphylococcus epidermidis NCTC® 13360 / ATCC® 12228

CHROMagar KPC
110329

10% Buffered Formalin- 60 ml
1026

Selectrol® Escherichia coli NCTC® 12241 / ATCC® 25922

Sabouraud Dextrose Agar w Gentamycin
111907

Mueller Hinton Agar 150
211305

Selectrol® Klebsiella pneumoniae (CRE) NCTC® 13440

Selectrol® Listeria innocua NCTC® 11288 / ATCC® 33090

Selectrol® Citrobacter freundii NCTC® 9750 / ATCC® 8090

Pseudomonas Agar P
111606

Cetrimide Agar 60MM
113001

Selectrol® Enterobacter cloacae NCTC® 13380 / ATCC® 23355

Selectrol® Pseudomonas paraeruginosa NCTC® 12924 / ATCC® 9027

Corn Meal Agar
110310

Mueller Hinton Blood Agar
111306

Selectrol® Legionella pneumophila serogroup 1 NCTC® 11192 / ATCC® 33152

Gram's Crystal Violet
1001

GBS / Columbia CNA Blood Agar
120409

Loweinstein-Jensen (LJ) Slants
4321387

Baird Parker Agar 90MM
110204

SABHI Agar Slants
4321014

Columbia Agar
110311

MacConkey Agar w/o Salt
111312

Selectrol® Escherichia coli NCTC® 12923 / ATCC® 8739

Selectrol® Listeria monocytogenes NCTC® 10527 / ATCC® 13932

Gram Negative Broth
4321729
%20Agar%201.png)
BCYE (Buffered Charcoal Yeast Extract) Agar
110213

Salt Broth 6.5%
419001

Xylose Lysine Desoxycholate (XLD)Agar
112401

Phenylethyl Alcohol Agar w 5% Sheep Blood
111616

Normal Saline - 300 ML
1035

BHI Blood Agar w Chloramphenicol & Gentamicin
110220

Todd Hewitt Broth
412005

Diabetica Travel Bag
110203

Selectrol® Enterococcus faecalis NCTC® 12697 / ATCC® 29212

Selectrol® Pichia kudriavzevii NCPF® 3100

Diluting Fluid A
1043

Desoxycholate Citr. Lact. Sucr. (DCLS) Agar
110403

Selectrol® Streptococcus dysgalactiae subsp. equisimilis NCTC ® 13762

Selectrol® Escherichia coli NCTC® 11560

Haemophilus Test Agar
110803
.svg)

.svg)



.svg)